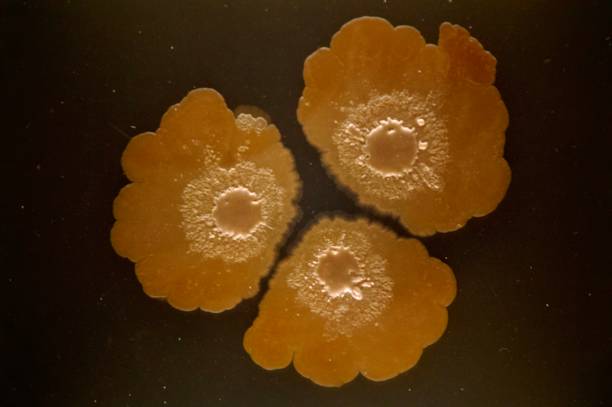
中马吉孕：高龄试管着床八周胎停还能保胎吗？

中马吉孕:试管婴儿连续失败是什么原因?
在试管婴儿医治过程中,由于涉及到各种药物医治以及手术操作,或许会对我们的身体和心思上发生不同程度的损害,尤其是遭遇接连失利时,除...
阅读详情电话:19919999145
微信:17027022222
邮箱:kf@daiyun.cn
地址:国内、马来西亚、吉尔吉斯斯坦
试管婴儿怎么做的 第2页

在试管婴儿医治过程中,由于涉及到各种药物医治以及手术操作,或许会对我们的身体和心思上发生不同程度的损害,尤其是遭遇接连失利时,除...
阅读详情
促排期间对孕酮的要求是正常就好,不高也不低,这是因为孕酮低会影响促排卵的效果。正常情况下,女性在促排卵期间孕酮过高或过低都是不好...
阅读详情
...
阅读详情
基因选择对女性不会有痛苦,因为基因选择一般都是通过生化检测、DNA分析以及染色体分析进行的,而这些检查的查验物都是来源于羊水、血...
阅读详情
试管d5和d6胚胎其实就是指试管第5天和第6天的胚胎,两者之间并没有太大的不同,只是时刻上的差异。别的,试管移植囊胚都只能移植一...
阅读详情
试管卵泡期长效方案的优势很多,像可控性强、妊娠率稳定、范围宽等,尤其是对于多囊卵巢、子宫腺肌病、子宫肌瘤女性来说,医院都会推荐选...
阅读详情
正常情况下,促排取卵比较少才会选择连续促排攒胚胎。一般来说试管可以连续促排卵,但取卵次数一般不超过3次,当然,攒卵不一定每次都需...
阅读详情
正常情况下,三代试管技术主要通过选择健康胚胎进行移植来减少某些遗传性疾病的发生概率,但对于白内障这类非常见的遗传性疾病,却无法进...
阅读详情
一般来说,三次生化妊娠是可以继续试管的,但是具体情况还是要看试管女性的身体状况。正常情况下,多次生化妊娠和染色体异常、精卵质量有...
阅读详情
试管促排针是不会伤害皮肤,但是有些女性对促排药物过敏,会出现红肿、皮疹,同时打了促排针有可能会长痘,因为突然注射雌激...
阅读详情
ca125指数高,并不意味着试管婴儿治疗一定会失败。尽管子宫内膜异位可能会对试管婴儿的成功率产生一定影响,但并不排除...
阅读详情
哥伦比亚代孕法律现状:漏洞与争议随着现代生殖技术的快速发展,代孕作为一种生育方式在全球范围内引发了广泛关注。然而,哥伦比亚在这一...
阅读详情
澳大利亚 在澳大利亚,所有司法管辖区都允许利他代孕;商业代孕属于刑事犯罪。在新南威尔士州、昆士兰州和澳大利亚首都地区,...
阅读详情
在巴西,法律规定禁止商业代孕,然而非法的商业代孕却在全国范围内大量上演。这不仅违反了法律,也损害了公众利益和人类尊严。本文将探讨...
阅读详情
愛之晶海外國際醫療轉介有限公司 中马吉孕 海外转诊试管助孕医疗服务 二代试管只配成1个胚胎,要根据...
阅读详情
愛之晶海外國際醫療轉介有限公司 中马吉孕 海外转诊试管助孕医疗服务 三代试管婴儿成功着床后,孕囊却...
阅读详情
愛之晶海外國際醫療轉介有限公司 中马吉孕 海外转诊试管助孕医疗服务做试管的全流程分为12步,步骤多是因为试管...
阅读详情
愛之晶海外國際醫療轉介有限公司 中马吉孕 海外转诊试管助孕医疗服务移植4ab囊胚的胎儿性别不一定,有的人觉得...
阅读详情
愛之晶海外國際醫療轉介有限公司 中马吉孕 海外转诊试管助孕医疗服务连续两次试管失败内膜很好,黄体功能不足只是...
阅读详情
愛之晶海外國際醫療轉介有限公司 中马吉孕 海外转诊试管助孕医疗服务NGS试管和PGD试管的区别在于NGS试管...
阅读详情
愛之晶海外國際醫療轉介有限公司 中马吉孕 海外转诊试管助孕医疗服务连续强阳的情况下,一般建议在阳后第14天左...
阅读详情
愛之晶海外國際醫療轉介有限公司 中马吉孕 海外转诊试管助孕医疗服务试管前阴超子宫连续性差一般不建议做试管婴儿...
阅读详情
愛之晶海外國際醫療轉介有限公司 中马吉孕 海外转诊试管助孕医疗服务试管长效长方案一般指的是长效促性腺激素释放...
阅读详情
愛之晶海外國際醫療轉介有限公司 中马吉孕 海外转诊试管助孕医疗服务第三代试管婴儿可以做龙凤双胞胎,但具体需要...
阅读详情
愛之晶海外國際醫療轉介有限公司 中马吉孕 海外转诊试管助孕医疗服务3天的冻胚移植后第9天hcg数值并没有严格...
阅读详情
愛之晶海外國際醫療轉介有限公司 中马吉孕 海外转诊试管助孕医疗服务24岁女性试管可以放2个胚胎,但是要根据移...
阅读详情
愛之晶海外國際醫療轉介有限公司 中马吉孕 海外转诊试管助孕医疗服务正常情况下,34岁及其以下的女性做试管龙凤...
阅读详情
愛之晶海外國際醫療轉介有限公司 中马吉孕 海外转诊试管助孕医疗服务44岁试管着床8周胎停一般是不能保胎,建议...
阅读详情
愛之晶海外國際醫療轉介有限公司 中马吉孕 海外转诊试管助孕医疗服务二代试管受精卵没形成可移植胚胎,一般是不能...
阅读详情
愛之晶海外國際醫療轉介有限公司 中马吉孕 海外转诊试管助孕医疗服务一般来说,促排卵泡成熟但是不破裂不一定要做...
阅读详情